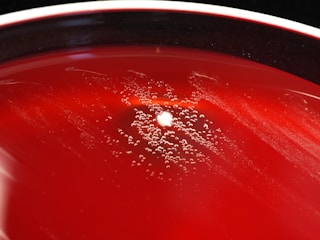

Methodology
Integrating advanced imaging technology with AI for biological interpretation.










Advanced Imaging
Integrating imaging technology with AI for biological interpretation.


Sample Analysis
Developing systems for comprehensive microorganism data capture.


Global Database
Compiling structured marine microorganism data with imagery.

AI Framework
Utilizing GPT-4 for advanced data analysis techniques.
Innovative Solutions
Creating methodologies for enhanced biological interpretation.
Our Methodology
Integrating advanced imaging technology with AI for comprehensive biological interpretation of marine microorganisms.



